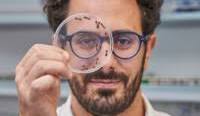

Serafino Teseo
Mis
à jour le
26-Fév-2025
Serafino Teseo

Thèse 2009-2013 à Paris 13 : "Conflits et coopération dans les sociétés de la fourmi clonale Cerapachys biroi" sous la direction de Pierre Jaisson et Nicolas Châline (Paris 13).
"J'ai quitté les insectes sociaux et la recherche academique parce que je ne trouvais plus de boulot. Je fais de la recherche pour une entreprise sur Paris. C'est moins passionnant mais il faut s'adapter !" (mail du 25 février 2025)